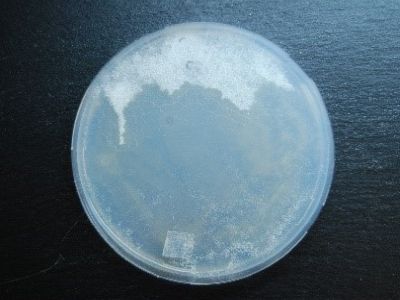
123 1
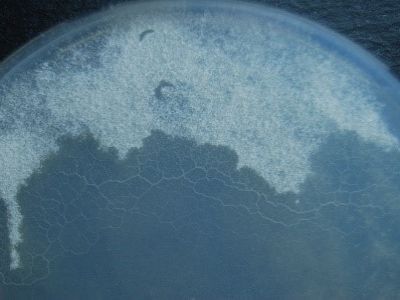
WP241 2

SCHLEIMPILZE ALS POTENTIELLE GEGENSPIELER ZU FUSARIUM-WELKE BEI TOMATEN
Untersuchung der räuberischen Aktivität von Schleimpilzen (Myxomyceten) gegenüber dem Fusarium-Welkeerreger Fusarium oxysporum f. sp. lycopersici bei Tomatenkontrollen
Myzelium von Fusarium, das von einem Plasmodium eines Schleimpilzes attackiert wird
Foto: Johann Gangl
Myzelium von Fusarium, das von einem Plasmodium eines Schleimpilzes attackiert wird
Foto: Johann Gangl

40fache Vergrößerung eines Plasmodiums beim Attackieren von Fusarium Myzel
Foto: Johann Gangl
Schleimpilze (Myxomyceten) sind einzellige Mikroorganismen aus der Gruppe der Amöbozoen, die unter anderem auch im Boden vorkommen.
Myxomyceten haben in Laborkonfrontation mit pflanzenpathogenen Pilzen bereits räuberische Aktivität gezeigt. Sie sind in der Lage, das Myzel der pflanzenpathogenen Pilze - darunter diverse Fusarium-Arten - zu vernichten, in dem sie es als Nahrungsquelle nutzen. Nach jetzigem Stand sind uns keine Publikationen oder Anwendungen von Schleimpilzen als Gegenspieler zu Pflanzenpathogenen bekannt.
Dieses Projekt hat zum Ziel, das Wachstumsverhalten in den verschiedenen Lebenszyklusstadien von Schleimpilzen in bodenähnlichen Medien, und deren räuberische Aktivität gegenüber dem Fusarium-Welkeerreger der Tomate - Fusarium oxysporum f. sp. lycopersici - zu untersuchen. Zuerst soll geklärt werden, ob Schleimpilze in verschiedenen bodenähnlichen Substraten wachsen können, die auch für das Tomatenwachstum geeignet sind. Sind Schleimpilze in der Lage zu wachsen, wird geklärt, ob sie die Biomasse des Pflanzenpathogens in einem bodenähnlichen Medium reduzieren können. Am Schluss soll in Glashausexperimenten untersucht werden, ob die Schleimpilze die Symptome der von Fusarium ausgelösten Welkekrankheit bei Tomaten reduzieren können.
Dieses Projekt wird dazu beitragen, mehr über die Einsatzmöglichkeiten von Schleimpilzen als mögliche Gegenspieler von pflanzenpathogenen Pilzen im Boden zu erforschen und damit evenuell den Weg einer Anwendung einer komplett neuen Organismengruppe im biologischen Pflanzenschutz zu ebnen.
Lead Researcher:

Ao. Univ. Prof. Dr. Marc Lemmens
Universitätsdozent
Institut für Biotechnologie in der Pflanzenproduktion, Universität für Bodenkultur Wien
marc.lemmens@boku.ac.at
+43 1 47654-97104
www.boku.ac.at





